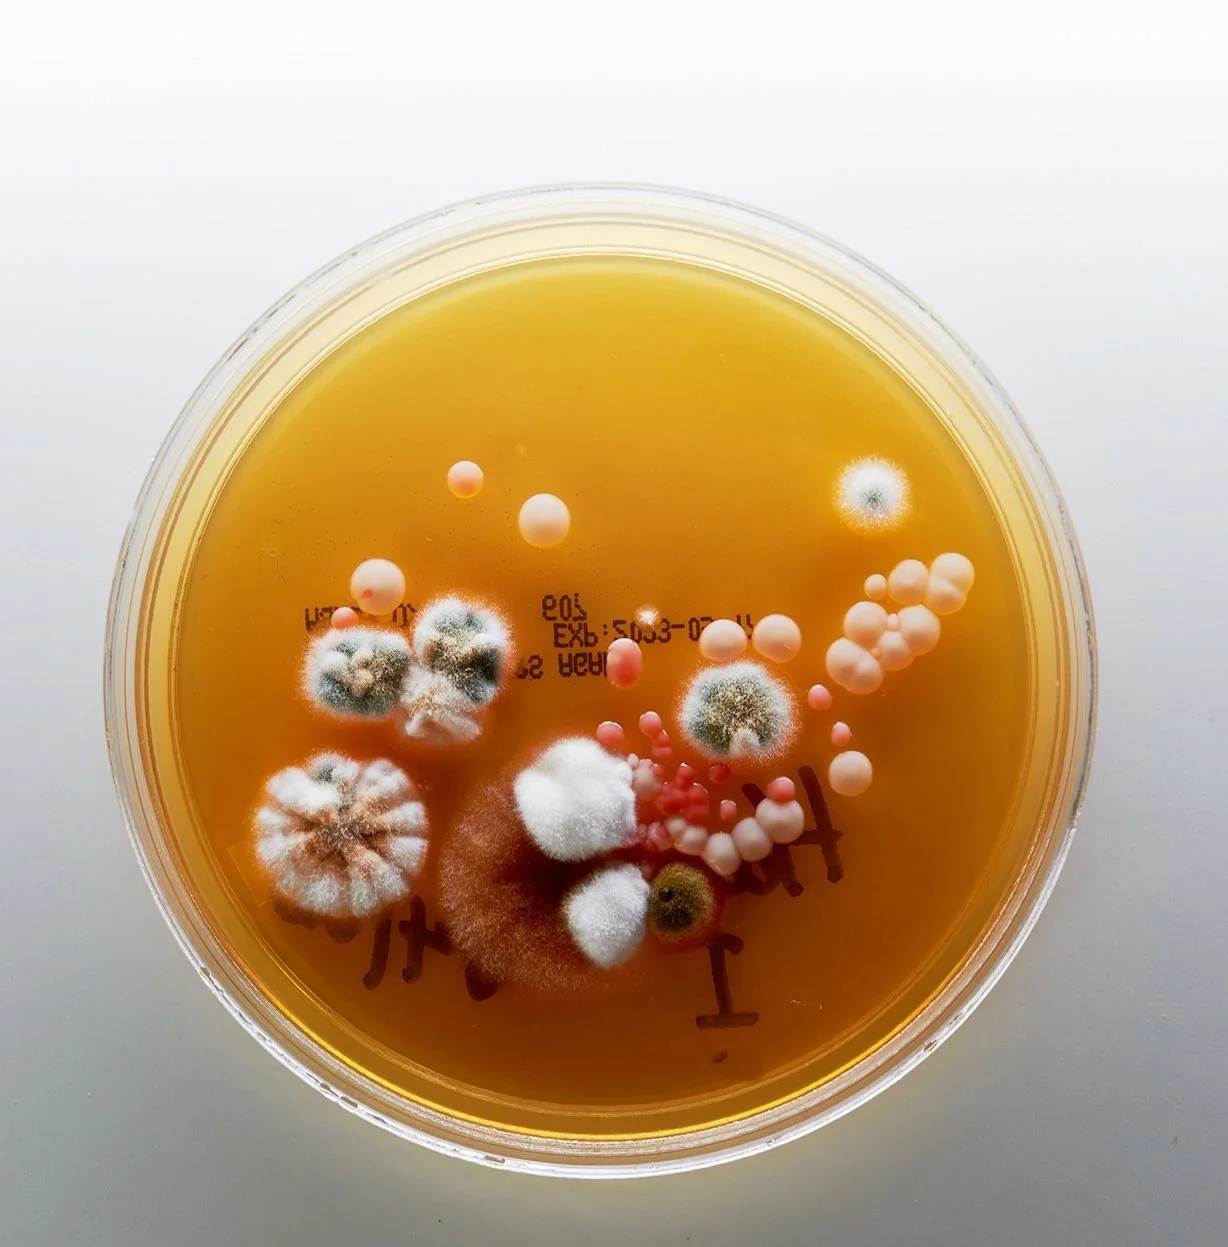
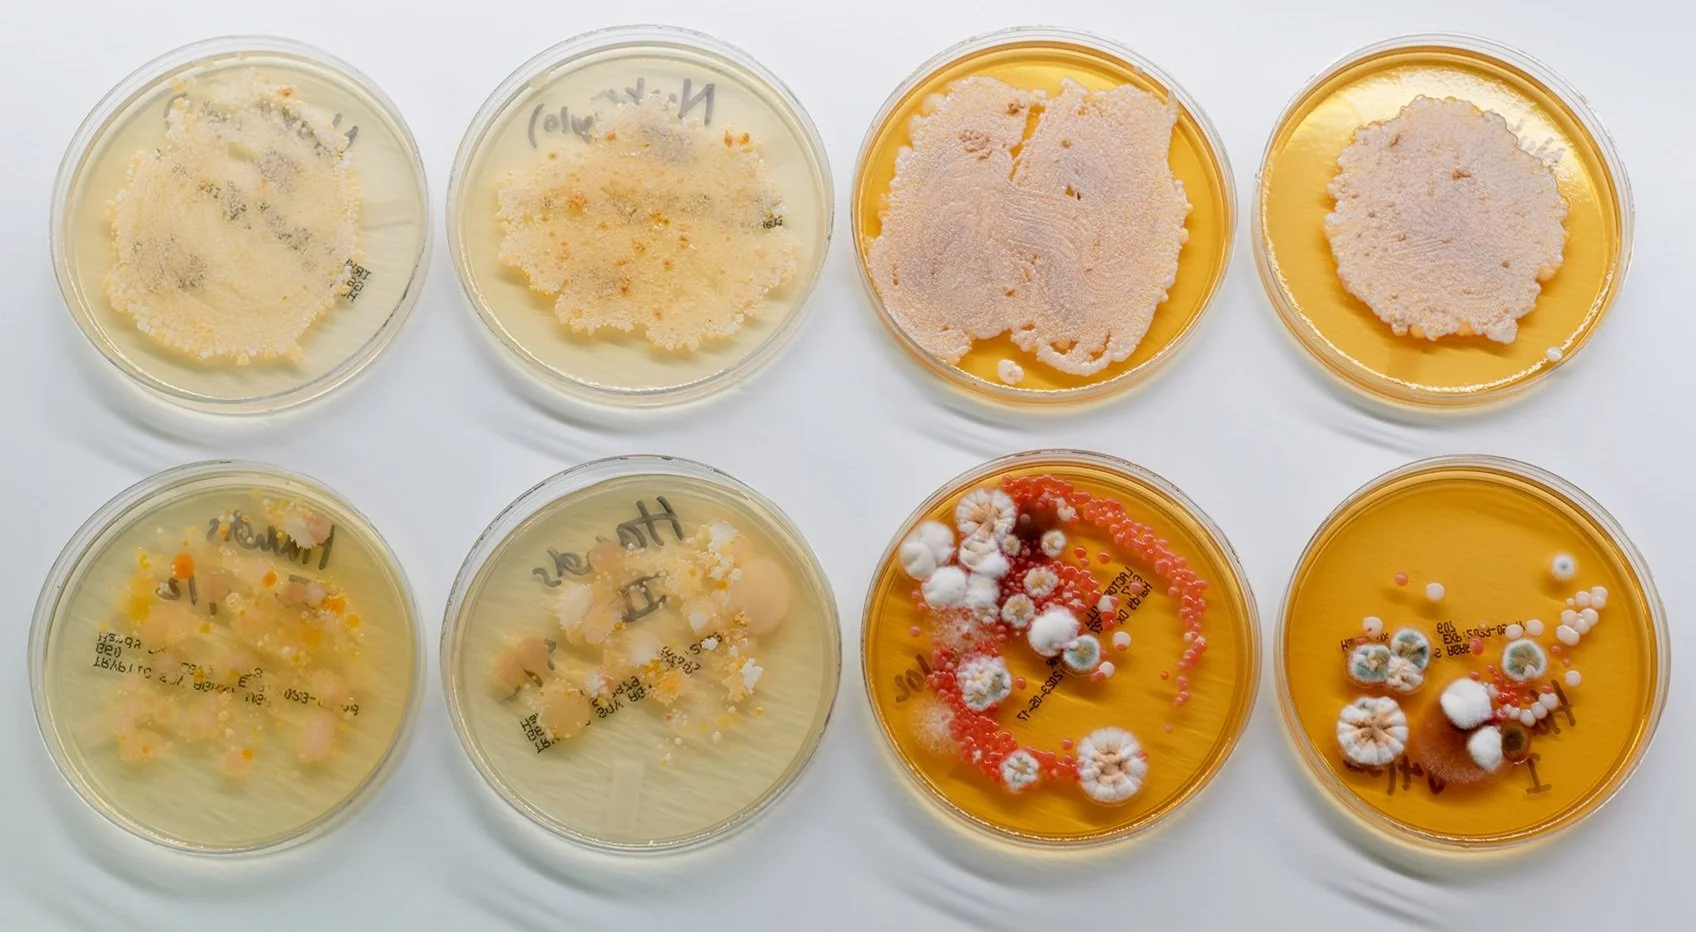

Finger-, Tongue-, Teeth-, Nose- and Eareyes
INTRODUCTION
In the original articulation of my relationship with nukadoko, I was worried about whether I had done a good enough job cultivating them, if I was doing a good enough job maintaining them, if my microbes were happy. In working with and caring for the nukadoko, I was searching for what working with and caring for the nukadoko said about me. Hoping that my involvement and care and work would help me tap into “a world of mutual interdependency and finitude, in contrast to neoliberal capitalist views of infinite limits and self-directed striving” (Fournier 2020). However, instead of accessing the beautiful, romantic, and interconnected world described by Fournier, I found I was struggling with basic maintenance:
Lately, I haven’t found joy in maintenance. Not in caring for the nukadoko, nor in taking care of myself nor my environment. Outside of the refrigerator where my nuka waits patiently to be handled and fed, dishes are piling up. Mail is stacked on the counter. Laundry hides behind my bathroom door. We both need to be refreshed, aerated, taken care of, but I don’t have the capacity for either of us these days. (Hipol 2023)
In seeing myself as central to the process of fermentation — and thus responsible for any failure that might occur — I wasn’t living into the ethos of “cooking with” (Hipol 2023) and thus approached fermentation as just a project outside of myself. Despite my attempts to do otherwise, I couldn’t escape the perspective of “the human individual as a billiard ball, a self-contained creature for whom relationships with other creatures are accidental to us, not parts of our essence” (Heldke 2018).
Initially, this project was meant to build onto my initial approach to the nukadoko: I cultivated the microbes from my hands and from the nuka onto two types of agar plates (Tryptic Soy Agar and Lactobacilli MRS Agar) with the intention of finding evidence of myself in the nuka plates (to my untrained eye, I couldn’t find any). After starting from the “question of whether the microbes are there or not (they are)” (Hey 2021) and not finding the answers I had hoped for, I returned to simply maintaining the nuka and paying attention to how it responds to different inputs (vegetables and fruits) as a way of exploring what it means to be a relational or collective organism (Heldke 2018).
Figure 1: Cultivated TSA plates (left 2 columns) and Lactobacillus MRS agar plates (right 2 columns). The plates in the top row are from the nukadoko, and the plates in the bottom row are from my hands. Photo by Arkan Zakarhov.
AGAR HUBRIS
Immediately following the conclusion of the first expression of this project, in the thick of my melancholy and fermentation insecurity, I cultivated the microbes from my hands and from the nukadoko. I had hoped and expected to see crossover and contamination between the microbes on my hands and the nukadoko (Figure 1). On April 2, I inoculated two types of agar plates (Tryptic Soy Agar (TSA) and Lactobacilli MRS Agar) to cultivate isolated Lactobacilli along with any other microbes that might be present on either of us. In total I inoculated eight plates — two each of each type of growing medium for my hands and for the nuka — in case I had made a mistake with any of them. To keep the plates safe from my cat and shield them from other possible contaminants or physical disturbances, I stored the plates in my spice cabinet for four days to let them grow. On April 6, I checked back in on them and then moved them to the fridge to slow their growth.
Figure 2: Plate storage in my spice cabinet (left) and top shelf of my fridge (right). Please note the mold in the neighboring container of leftovers and think about Heldke’s “citizen of the refrigerator” (2018). Photos by Shelby Hipol
Contrary to my expectations, similarities between microbes from the nuka plates and the hand plates weren’t immediately evident to my untrained eye. All four nuka plates (regardless of growing medium) were consistent in their off-white and pale orange colonies bubbling out from where the nuka had made contact with the agar. However, the Lactobacillus MRS agar hand plates erupted in bulbous pinks and blossomed with teal, brown and white mold, while the TSA plates were more demure with pale yellows, oranges and whites scattered across the surface in lacy patterns. In these plates, I was hoping to see evidence of “an even more intimate association with human fermenters” (Hom and Penn 2021). Instead, in the plates I found that “fermentation was not a human triumph over microbes but a service in reverse; fermentation happens when humans enable microbes to do it” (Hey 2021).
Figure 3: Side by side comparison of hand plates (top row) and nuka plates (bottom row) on TSA plates (left column) and Lactobacillus MRS plates (right column).
Originally, I had planned on creating a second nukadoko bed that incorporates contact and interaction from members of my community (friends, acquaintances, colleagues, and classmates) and then cultivate new agar plates to see how the microbes and the resulting products of fermentation might be transformed by my community’s contributions. However, after seeing the plates and “meeting” the microbes, I wasn’t certain that I’d be able to see or even understand the difference, if there was one. At this point I wasn’t sure about what I was looking for in the nuka anymore, and in retrospect, by framing the project around this expectation of transformation based on my and my community’s involvement in the nukadoko, I exposed a naïve sense of self-importance in myself and in human fermentation partners overall. These realizations necessitated a reconfiguration of how I saw my role in the lives of the microbes: Was I their mother? Keeper? Friend? Caregiver? And what would each of these roles say about me?
FINGER-, TONGUE-, TEETH-, NOSE- AND EAREYES
At this point I felt like I was back at square one. My expectations needed to be re-examined. In this phase of unknowing, I continued to maintain and feed the nuka while working through the next stage of the project. Through this care and maintenance, I began attuning to changes in the nukadoko, learning how it reacts to different vegetables and feeling, tasting, smelling, and hearing changes in its form using my finger-, tongue-, teeth-, nose- and eareyes as inspired by Eva Hayward:
“Responsiveness to the textural qualities of experimentation is part of any ethical account, any nonanthropocentric record, of what happens when species touch each other in fraught zones of intercourse”
In “Touch Fermentation,” the nukadoko felt and sounded like sand barely bound together with moisture, as though the nuka grains were maintaining their individualism. I was also “clumsy and didn’t know how much pressure I needed to break up the mixture, so I frequently overestimated and flung chunks of rice bran across my kitchen” (Hipol 2023) when caring for the bed and the microbes within it. Now that we’ve been living together and interacting with each other for almost three months, the nuka has gotten softer and more wet, thanks to the daikon radish and cucumbers planted in the bed and lending their moisture. Scraping, scooping, and fluffing the nuka sounds and feels like I’m molding something out of playdoh, soft yet scratchy at the same time. Bits of nuka cling to my hands and the vegetables. I do my best to keep it all inside its container. The smell is hard to describe, like a toasted earthiness. After spending two to four days buried in the bed, vegetables emerge salty, a little softer than when they went it, and infused with the nuka’s scent. I added some green beans to the bed, and afterwards they retained an essential green bean-ness at their core but outwardly reflected the flavor of the nukadoko paste. When pressing the nuka back into its bed after being scraped, scooped, and fluffed, my palm clings to it a little and makes a damp sound like two wet bodies coming together.
I’m more sure in my movements now as I mix the nukadoko, no longer worrying if I’m doing it right or if the microbes are there (they are). I find pleasure in feeding the microbes, delighting in the ways that they respond to new foods. I learn to see our collaboration as artmaking. And I learn to see our artmaking as emplacement, described by David Howes as “‘the sensuous interrelationship of body-mind-environment’” (Hayward 2010). While in “Touch Fermentation” I had seen the nukadoko, living in its container on a shelf in my fridge, as separate from the surrounding mess of my kitchen and my own emotional struggles, becoming attuned with the nuka gave me a model of attunement with myself. Like how the nukadoko communicates its needs through its texture and flavor and smell, I was subconsciously doing the same in my own environment, evidenced by the piles of unopened mail, dirty dishes and recycling spilling out across my counters.
“Everything I say is Art is Art. Everything I do is Art is Art” (Ukeles, 1969)
EMBRACING THE RELATIONAL SELF
Last summer my friend Park and I went for a walk around the time I unexpectedly had to move. After walking around Brooklyn for a couple hours, we landed at my apartment for some water before they headed home. My kitchen table was obscured by dishes, unopened mail, recycling I hadn’t yet taken out. Embarrassed about Park seeing evidence of my failure to take care of myself, I started to sort the mail and papers into piles and collect the recyclables into another pile despite their reassuring me that it was fine and not to fuss. After I continued to apologize and fuss, explaining that I was just stressed about having to move and worried about where I’d land, my friend handed me the piles of mail I had made moments prior and told me to go through it while they did the dishes. I wept with relief and appreciation and grief. It's not easy for me to ask for help, and it took my friend being attuned to my needs and feelings that I had been holding in to make me recognize my own needs.
Similarly, as I was writing “Touch Fermentation” I was going through a hard time, and it took talking and thinking about how I was having a hard time maintaining the nukadoko within the mess of my apartment to recognize my needs instead of just feeling guilty about my perceived failures. In the accompanying video, you can watch me clean my apartment over the course of five and a half hours (condensed into five and a half minutes). During this time, I thought about myself — the solid part that acts and makes decisions — as a symbiont to myself — the soft part that feels and reacts — collaborating to take care of my environment — the physical space that all parts of myself inhabit and express themselves through. In being observed and in observing myself, I try to imagine myself as the microbes in the nuka that are making do with the food, moisture, and oxygen available to them in the space they inhabit. I once again had to reframe the nukadoko symbiosis from being between just the microbes and myself to now include the wider environment in which we both live.
CONCLUSIONS
The nuka and I are in collaboration with each other within a wider world of relational existence. It’s not just us in symbiosis with my apartment. It’s with the land where the rice was grown alongside its resident microbes. The person who polished the rice. The farmers and distributors and store associates who facilitated the connection between me and the rice bran and with the vegetables that sustain the nukadoko. It’s the people with whom I’ve shared the products of fermentation.
Although I still distrust the romanticization of fermentation, I’ve come to embrace it as wet, emplaced collaboration in which all the different participants don’t have to mean anything because we all just “are.”
SOURCES
Fournier, Lauren. 2020. “Fermenting Feminism as Methodology and Metaphor: Approaching Transnational Feminist Practices through Microbial Transformation.” Environmental Humanities 12 (1): 88–112. doi: https://doi.org/10.1215/22011919-8142220
Hayward, Eva. 2010. “Fingereyes: Impressions of Cup Corals.” Cultural Anthropology 25 (4): 577–599.
Heldke, Lisa. 2018. “It’s Chomping All the Way Down: Toward an Ontology of the Human Individual.” Monist 101 (3): 247-60. https://doi.org/10.1093/monist/ony004.
Hey, Maya. 2021. “Attunement and Multispecies Communication in Fermentation.” Feminist Philosophy Quarterly 7 (3). Article 4. https://doaj-org.proxy.library.nyu.edu/article/c084f8394f2143e2ac41afcebbda2a7e.
Hipol, Shelby. 2023. “Touch Fermentation: Musings on Care, Community and Collaborative Labor.”
Hom, Erik, and Penn, Alexandra. 2021. “Symbiosis and the Anthropocene.” Symbiosis 84: 239–270. https://doi.org/10.1007/s13199-021-00794-0.
Ukeles, Mierle Laderman. 1969. “Manifesto for Maintenance Art,” QueensMuseum.org. https://queensmuseum.org/wp-content/uploads/2016/04/Ukeles-Manifesto-for-Maintenance-Art-1969.pdf.
van Dooren, Thom; Kirksey, Eben; and Münster, Ursula. 2016. “Multispecies Studies: Cultivating Arts of Attentiveness.” Environmental Humanities 8 (1): 1–23. http://read.dukepress.edu/environmental-humanities/article-pdf/8/1/1/408987/1vanDooren.pdf.